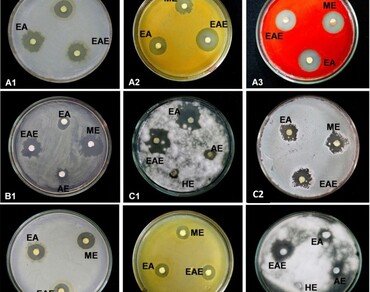
Antimicrobial potential of in vitro and in vivo plant parts of Paeonia emodi Wallich Ex Royle (Himalayan peony)

Vol 36 Issue 2, June 2023
Total Articles: 44

Medicinal plants traditionally used in the Algerian Sahara: an ethnobotanical study
Research Articles
Views: 5665
Pages: 400-426
Published: 25 July, 2022
Doi: 10.1007/s42535-022-00423-1

Different spectral qualities do not influence the in vitro and ex vitro survival of Epidendrum denticulatum Barb. Rod.: a Brazilian orchid
Research Articles
Views: 3939
Pages: 427-441
Published: 09 August, 2022
Doi: 10.1007/s42535-022-00440-0

Medicinal plants used for the treatment of cancer in Algeria: an ethnomedicinal survey
Research Articles
Views: 4119
Pages: 442-452
Published: 04 August, 2022
Doi: 10.1007/s42535-022-00445-9

Evaluation of the potential yield and associated component traits of lowland Boro rice cultivars in Assam, India
Research Articles
Views: 3655
Pages: 453-463
Published: 13 July, 2022
Doi: 10.1007/s42535-022-00426-y
![Influence of priming treatments on germination, seedling growth and survival of China aster [Callistephus chinensis (L.)]](/images/journal/vegetos/article/631cd76a5b267.webp)
Influence of priming treatments on germination, seedling growth and survival of China aster [Callistephus chinensis (L.)]
Research Articles
Views: 3516
Pages: 464-473
Published: 06 July, 2022
Doi: 10.1007/s42535-022-00416-0

Evaluation of stigma receptivity and its properties in Helianthus annuus L. (Asteraceae)
Research Articles
Views: 3649
Pages: 474-483
Published: 06 July, 2022
Doi: 10.1007/s42535-022-00419-x

Screening of heavy metal stress tolerant fungal isolates for bioremediation and restoration of soil health
Research Articles
Views: 3801
Pages: 484-493
Published: 23 June, 2022
Doi: 10.1007/s42535-022-00417-z
Antimicrobial potential of in vitro and in vivo plant parts of Paeonia emodi Wallich Ex Royle (Himalayan peony)
Research Articles
Views: 3793
Pages: 494-505
Published: 18 June, 2022
Doi: 10.1007/s42535-022-00408-0

ROS production and antioxidant enzyme activity in relation to germination and vigor during tobacco seed development
Research Articles
Views: 3825
Pages: 506-515
Published: 16 June, 2022
Doi: 10.1007/s42535-022-00412-4